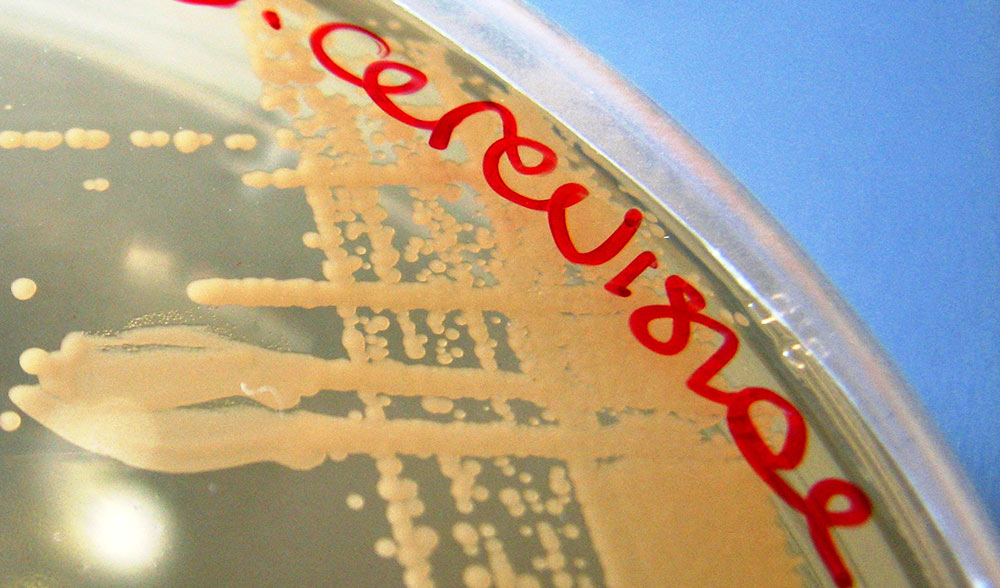
Unsplashed background img 3

Safale S-04 is an English top-fermenting yeast from Fermentis, which I mostly use for IPAs with a certain fruity note. It is characterised by fast fermentation (3-4 days) and high flocculation of proteins and yeast residues, resulting in a fairly clear beer.